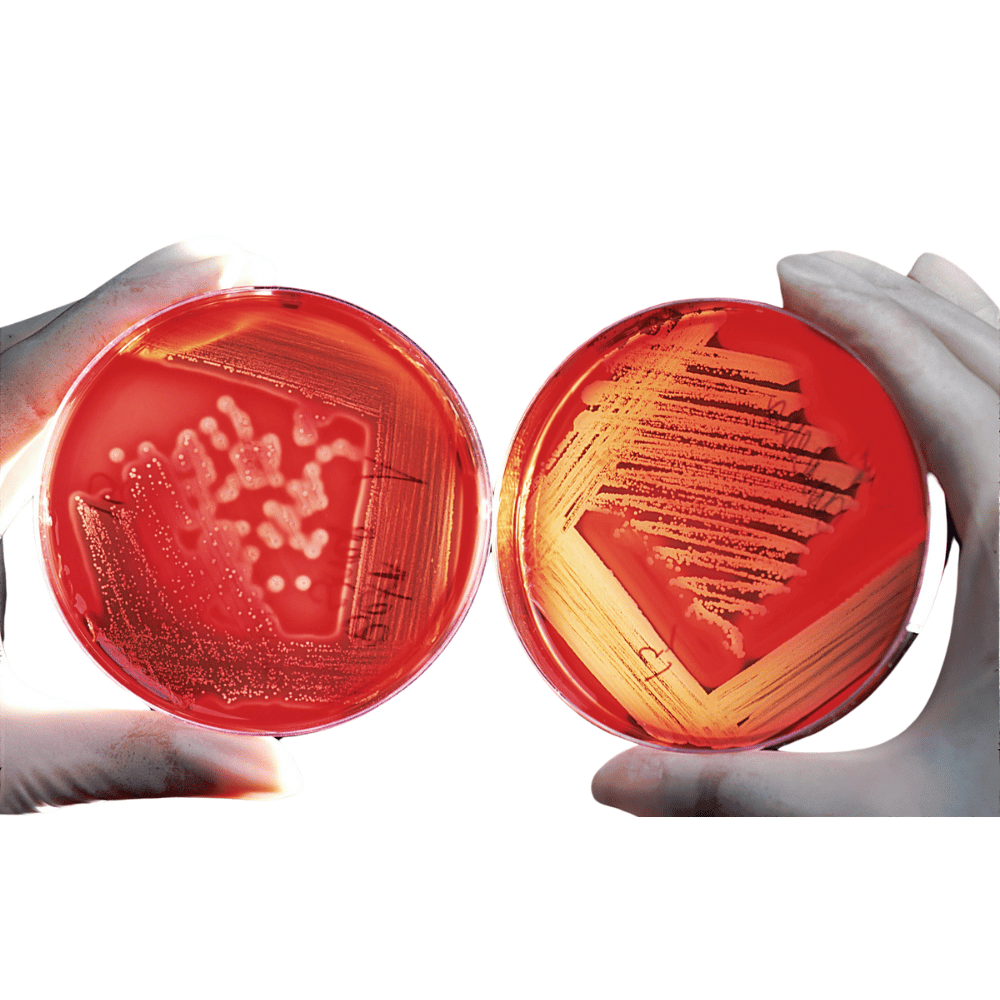

Reines Aloe-Vera-Ergänzungsmittel aus Blattinnenextrakt – Vitamin Shot – 100 % Aloe Vera
500ml
Beginnen Sie Ihren Tag richtig mit einem 100 % reinen Aloe Vera-Präparat. Wenn Sie nach einer natürlichen und gesunden Ergänzung Ihrer Ernährung suchen, ist dies die Antwort.
Curaloe Aloe Vera Vitamin Shot wird aus reinem Aloe Vera-Blattextrakt (inneres Blatt, kein Fruchtfleisch) hergestellt. Curaloe Aloe Vera Vitamin Shot enthält alle Vitamine und Mineralien, die zur Unterstützung eines gesunden Immunsystems, einer normalen Magen-Darm-Funktion und zur Förderung eines gesunden, gut stabilisierten Verdauungssystems erforderlich sind. Curaloe Aloe Vera Vitamin Shot ist eine großartige Alternative zur Einnahme mehrerer Vitamine und Mineralien und versorgt den Körper mit einer Fülle lebenswichtiger Nährstoffe und Mineralien. Der reine Aloe Vera-Blattextrakt (inneres Blatt) ist von Natur aus reich an wichtigen Polysacchariden und Aminosäuren. Diese unterstützen unser Immunsystem und fördern eine gesunde Immunantwort.
Vorteile:
- Hilft, körperliche Ermüdung und Müdigkeit zu reduzieren.*
- Unterstützt eine normale Darmfunktion.*
- Wirkt sich positiv auf das Immunsystem aus.*
- Unterstützt eine gesunde Haut.*
Ein täglicher Shot (1fl.oz) enthält:
- Vitamin: A, B1, B2, B3, B6, B12, C, E.
- Folsäure und Cholin
- Kalzium, Magnesium, Zink, Chrom, Selen, Natrium, Eisen, Kalium, Kupfer und Mangan
Gebrauchsanweisung:
- 1 Flasche = 17-tägige Kur
- Trinken Sie täglich 30 ml Curaloe Health Supplement, pur oder gemischt mit Wasser oder Fruchtsaft
Frei von: Gluten, Weizen, Hefe, Soja, Mais, Milchprodukten und Zucker.
Es wurden keine Farbstoffe hinzugefügt.
Zutatenliste:
Aloe Barbadensis (Vera) Blattsaft, Zitronensäure (E330, Säureregulator), Natriumerythorbat (E316, um die Frische zu bewahren), Kaliumsorbat (E202, um die Frische zu bewahren), Natriumbenzoat (E211, um die Frische zu bewahren)
*Haftungsausschluss*: Diese Aussagen wurden von der Food and Drug Administration nicht geprüft. Dieses Produkt ist nicht zur Diagnose, Behandlung, Heilung oder Vorbeugung von Krankheiten bestimmt.

Natural Ingredients

Gentle for All

Cruelty-Free
Directions For Use
Ingredients
Optionen auswählen

Reines Aloe-Vera-Ergänzungsmittel aus Blattinnenextrakt – Vitamin Shot – 100 % Aloe Vera
Why It’s Special
Hero Ingredients
Discover the power of nature with our carefully selected ingredients, each chosen for their unique benefits, providing your skin with the nourishment it craves for a radiant and youthful appearance

Why It Works
Aloe Vera Juice
Why It Works
Polysaccharides

Why It Works
Amino Acids